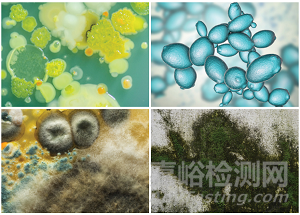
抗菌添加劑的新應(yīng)用與技術(shù)發(fā)展

您當(dāng)前的位置:檢測資訊 > 科研開發(fā)
嘉峪檢測網(wǎng) 2022-08-16 22:20
自2020年初新冠疫情開始以來,對在多種應(yīng)用中使用的塑料中加入抗菌解決方案的興趣已大大增加。許多供應(yīng)商報告了多個市場的強(qiáng)勁需求,其中最大的興趣來自醫(yī)療保健、包裝、服裝和運輸領(lǐng)域,還包括保護(hù)膜和經(jīng)常觸摸的表面。
摻入塑料中的殺菌劑可保護(hù)最終產(chǎn)品免受微生物攻擊,延長產(chǎn)品壽命。如果存在最佳生長條件,真菌、藻類和細(xì)菌就可能會附著在塑料物品體內(nèi)或表面并降解塑料。微生物的生長會導(dǎo)致表面起斑、凹坑、結(jié)構(gòu)強(qiáng)度降低、變脆、電導(dǎo)率或柔韌性變化、氣味不良以及其他物理或機(jī)械性能變化。
抗微生物解決方案的開發(fā)商和生產(chǎn)商已經(jīng)在開發(fā)新產(chǎn)品方面投入更多的精力,其中許多新產(chǎn)品基于天然產(chǎn)品。瑞士公司山寧泰(Sanitized)宣稱自己是塑料和紡織品天然氣味管理、抗菌衛(wèi)生功能以及材料保護(hù)方面的領(lǐng)導(dǎo)者。“在疫情期間,我們注意到對公共和私人空間中清潔表面和衛(wèi)生的需求不斷增長,”聚合物添加劑產(chǎn)品經(jīng)理Christine Niklas說道,“第一次封鎖增加了對私人領(lǐng)域應(yīng)用的需求。例如,廚房的清潔變得越來越重要,現(xiàn)在仍然如此。同時,公共區(qū)域的衛(wèi)生也仍然備受關(guān)注。我們在全球觀察到了這一趨勢,即使在疫情之后,肯定還會繼續(xù)。”
Niklas說,市場對能提供廣泛保護(hù)的產(chǎn)品的需求正在增加。“我們最近完成了山寧泰Broadtec產(chǎn)品家族的開發(fā),現(xiàn)在可以為各類應(yīng)用和需求承接訂單。該系列產(chǎn)品適用于各種制造工藝,例如壓延、擠出、注塑成型和噴涂。”
圖:據(jù)稱山寧泰的Broadtec抗菌產(chǎn)品家族對細(xì)菌(左上方)、 酵母(右上)、霉菌(左下)和藻類(右下)有效。
圖片來源:山寧泰
總部位于美國的Microban International公司表示,將于今年晚些時候推出幾種新型的抗微生物產(chǎn)品。這些新產(chǎn)品包括一種新的抗菌化學(xué)品,該公司表示它可以在生產(chǎn)過程中無縫整合到低溫聚合物中,實現(xiàn)持久抗菌效果,同時不會影響最終零件的表面紋理、光學(xué)清晰度、顏色或耐用性。
“這種下一代技術(shù)的活性成分是自然發(fā)生、可持續(xù)、無毒的,并且不含重金屬。”Microban聲稱,“該添加劑還具有很好的化學(xué)穩(wěn)定性、熱穩(wěn)定性和紫外線穩(wěn)定性,并且已經(jīng)被批準(zhǔn)用于歐盟的食物接觸應(yīng)用。它將得到另一種已被證明有效的抗菌和抗真菌的新技術(shù)的補(bǔ)充,使它可以在制造時輕松地加入到PVC、PP、TPU和EVA產(chǎn)品中。它適用于室內(nèi)和室外使用,在汽車和屋頂市場等地區(qū)具有潛在的應(yīng)用。”
銀基抗菌劑的替代品
總部位于英國的Wells Plastics生產(chǎn)Bactiglas品牌的抗菌產(chǎn)品已有20多年。該品牌業(yè)務(wù)開發(fā)經(jīng)理Mike Wright表示,該公司最近開始探索新的創(chuàng)新抗菌添加劑,這些添加劑可能會脫離傳統(tǒng)的銀基添加劑,但仍符合監(jiān)管法規(guī)——歐盟生物殺滅劑法規(guī)(EU Biocidal Products Regulation- BPR)。根據(jù)指定的應(yīng)用,它們可以做成有機(jī)和無機(jī)的添加劑。
他說:“它們不僅是可以配混成母粒的添加劑,而且可以在生產(chǎn)制造后使用,例如織物、紡織品、粉末和濕顏料以及用于可持續(xù)紙板包裝的新涂層等應(yīng)用。”
新的應(yīng)用開始跨市場出現(xiàn)在建筑業(yè)。Wells說,將Bactiglas添加劑納入外墻覆層、管道和地板系統(tǒng)等建筑材料可以降低維護(hù)成本。該公司表示:“在建筑中使用抗微生物材料可以造就更可持續(xù)的項目,大大減少建筑對環(huán)境的影響。”
來自法國公司Pylote的抗微生物技術(shù)自2020年6月以來已在Pylote的合作伙伴Gergonne Industrie制作的Coversafe抗菌粘性膜中使用,這些粘性膜用于桌子和柜臺、窗戶、門把手、開關(guān)、扶手、支付終端等類似物品。自2020年9月以來,它還在另一個合作伙伴Adhetec生產(chǎn)的一系列特殊粘性膜中使用,用以保護(hù)航空公司座椅和屏幕。自2021年2月以來,它還已經(jīng)在Biotex Technologie的高保護(hù)Uns1織物口罩中使用。
今年3月,Pylote和主要包裝生產(chǎn)商貝里國際(Berry Global)宣布了戰(zhàn)略商業(yè)合作伙伴關(guān)系,合作涵蓋了抗菌包裝解決方案。第一個合作產(chǎn)品是Activated Rispharm,這是一種結(jié)合了高阻隔和抗菌保護(hù)的眼藥水滴瓶,據(jù)說對3型腺病毒(結(jié)膜炎)、大腸桿菌和金黃色葡萄球菌細(xì)菌有效。

圖:貝里國際與Pylote合作開發(fā)了抗菌包裝,例如這種眼藥水滴瓶。
圖片來源:PYLOTE / 貝里國際
Pylote的溝通專員Jean-Christophe Huertas表示,該公司的技術(shù)涉及將礦物陶瓷微球結(jié)合到塑料、油漆或清漆等材料中。“使用后,涂層表面被激活以殺死微生物。微球充當(dāng)凈化表面微生物的催化劑,并迅速、連續(xù)且穩(wěn)定地保護(hù)物品免受微生物污染,同時具有很高的安全性、效率和衛(wèi)生水平。”
擴(kuò)展選項
瑞士的海屹科(Heiq)是一家紡織品氣味控制和其他功能技術(shù)的重要參與者,它一直大量投資于塑料和涂料的新型內(nèi)置抗菌技術(shù)。去年,它收購了總部位于香港的Life Material Technologies和德國的RAS。前者銷售一種稱為Life Natural的基于植物的活性技術(shù),并銷售被領(lǐng)先的消費品塑料和工業(yè)品塑料以及涂料、紙張、纖維擠出和建筑材料廣泛使用的金屬和合成有機(jī)活性物質(zhì)。RAS提供歐盟生物殺滅劑法規(guī)(BPR)列出的金屬銀技術(shù),用于抗微生物、導(dǎo)電和抗病毒涂層化合物。
美國北卡羅來納州夏洛特市Heiq Life的銷售總監(jiān)Lisa Owen表示,該公司一直在與世界各地的商業(yè)合作伙伴一起開發(fā)和推出許多新技術(shù)。例如,海屹科 Hyprotecht是符合EPA和BPR的抗微生物母粒新產(chǎn)品系列,據(jù)說它在PC、PET、GPPS和PP等聚合物中提供了“近乎完美的”透明度。

圖:海屹科的新型HyProTEcht銀基抗菌母粒已經(jīng)在衛(wèi)生應(yīng)用中商業(yè)化。
圖片來源:海屹科
此外,為了響應(yīng)消費者對植物基和生物基解決方案的強(qiáng)烈需求,該公司正在使用天然植物提取物作為活性物質(zhì),推出了廣泛的符合EPA和BPR的母粒。HeiQ Life Natural母粒適用于TPE、TPU、EVA、PVC、PE和PP等加工溫度較低的聚合物,也用于顏料和透明改性材料。Heiq Life Natural母粒符合中國、美國和歐盟的食品接觸法規(guī)要求。
西班牙研究中心AIMPlas的化學(xué)技術(shù)研究人員Andrea Morandini和Lodovico Agostinis看到碳納米材料在開發(fā)“循環(huán)”生物基抗菌產(chǎn)品的過程中發(fā)揮了作用。他們說:“不同應(yīng)用領(lǐng)域?qū)Υ水a(chǎn)生了濃厚的興趣......各種應(yīng)用試圖遠(yuǎn)離普通添加劑例如金屬離子和銀、銅、鈦的氧化物,這些添加劑由于其可能的毒性和處理問題而受到審查。”
抗菌碳納米材料CNT
AIMPlas研究人員聲稱,他們最近發(fā)現(xiàn)碳納米材料顯示出強(qiáng)大的殺菌特性。“它們的抗菌機(jī)制很復(fù)雜,并取決于諸如組成成分和表面濃度等因素,但它們似乎能夠作用于細(xì)胞膜并破壞它們或引起氧化應(yīng)激,就像納米銀抗菌劑一樣。由于這些材料通過接觸發(fā)生作用時不釋放物質(zhì),因此它們適用于與身體不斷接觸的假體和植入體等醫(yī)療應(yīng)用。
從動物、植物和微生物提取物衍生的天然抗菌劑通常被認(rèn)為是安全且環(huán)保的。然而,天然抗菌肽,例如乳酸鏈球菌素、納他霉素、林可霉素、腸球菌素和乳酸片球菌素(已經(jīng)用于預(yù)防食物變質(zhì))對高溫敏感,使其難以在熱塑性材料中使用。Morandini和Agostinis說:“但是,它們可以封裝在多孔的無機(jī)或異質(zhì)結(jié)構(gòu)(無機(jī)/有機(jī)混合)基材中,這樣它們在加工過程中更耐高溫。”
“殼聚糖是研究最深入、使用最多的用于食品涂料和食品包裝的的生物聚合物之一,具有出色的抗菌特性。它是世界上最豐富的多糖,也是可生物降解和生物相容的。殼聚糖作為塑料應(yīng)用中的抗菌添加劑越來越重要,其衍生物被廣泛用作抗菌和抗氧化劑的天然替代品,尤其是在食品接觸應(yīng)用中。”
“抗菌劑抗性一直是醫(yī)院和醫(yī)療保健部門一個非常重要的問題。研究人員預(yù)測,開發(fā)不讓細(xì)菌和其他微生物產(chǎn)生抗性的新抗菌材料是醫(yī)療領(lǐng)域未來發(fā)展的關(guān)鍵領(lǐng)域。”
礦物質(zhì)殺菌劑
西班牙礦物添加劑公司托爾薩(Tolsa)提供三種不同的用于熱塑性應(yīng)用的殺菌劑產(chǎn)品,產(chǎn)品名為Adins Protection。其中兩種基于銀,另一種基于鋅。該公司的Adins技術(shù)可以在天然硅酸鎂里加入不同的活性物質(zhì)。這可以讓活性物質(zhì)在與之結(jié)合的基材中獲得最佳分布,托爾薩聲稱這造就了高抗菌活性。它還改善了活性物質(zhì)的熱和化學(xué)穩(wěn)定性,有助于最大程度地減少為達(dá)到既定保護(hù)水平所需的用量。目標(biāo)應(yīng)用包括自動化、塑料玩具、游泳池、室外家具以及建筑和醫(yī)院產(chǎn)品。
托爾薩最近與西班牙母粒專家Delta Tecnic合作,對用于游泳池的PVC配方中的抗菌活性進(jìn)行了一項研究,該配方使用了Adins Protection產(chǎn)品。“該配方PVC對游泳池中最常見的兩個細(xì)菌(大腸桿菌和銅綠假單胞菌)的殺菌性一得到證實,馬上就決定了在Suntest XXL+中進(jìn)行老化處理,該Suntest XXL+模擬一半(3000小時 )和全部(5000小時)的材料生命周期。“結(jié)果是老化處理后,對同一細(xì)菌的抗菌活性幾乎沒有變化。” (見圖1)。

據(jù)稱根據(jù)歐洲標(biāo)準(zhǔn)14476:2013+A2:2019,Adins Protection對所有包膜病毒也有作用,包括冠狀病毒類型、諾如病毒、輪狀病毒和腺病毒。這些產(chǎn)品還符合歐洲玩具安全指令(2009/48/EC)。Sacristán說:“我們有一些客戶將Adins Protection使用在玩具材料的配方中,目前這些配方正處于最終批準(zhǔn)階段。”
市場法規(guī)的變化
總部位于英國的Biocote解釋說,抗菌添加劑的使用在全球主要市場都受到嚴(yán)格監(jiān)管和控制。在歐洲,在市場上投放和使用殺菌劑產(chǎn)品要遵守歐盟生物殺滅劑法規(guī)BPR 528/2012(Biocidal Products regulation)。在美國,抗菌添加劑由環(huán)境保護(hù)署(EPA)負(fù)責(zé)管理,監(jiān)管法規(guī)是《聯(lián)邦殺蟲劑、殺菌劑與殺鼠劑法案》(FIFRA)。
Biocote指出,按照FIFRA,抗菌產(chǎn)品有兩類——殺蟲劑和經(jīng)過處理的物品。生產(chǎn)含抗菌技術(shù)產(chǎn)品的公司可以將其產(chǎn)品注冊為殺蟲劑,也可以當(dāng)作經(jīng)過處理的物品進(jìn)行銷售。殺蟲劑需要在特定類別中注冊,表明其使用方式。經(jīng)過處理的物品是一種為保護(hù)產(chǎn)品自身含有殺蟲劑的產(chǎn)品,并且只要滿足FIFRA里詳述的某些要求,就可以免除注冊的要求。該公司表示,注冊為包含抗菌添加劑的殺蟲劑產(chǎn)品可能是一個昂貴且漫長的過程。
Biocote表示,由于最近停止供應(yīng)吡啶硫酮鋅((ZnPT))的決定,它將法規(guī)符合性當(dāng)成了首要事項。它說,當(dāng)歐盟委員會于今年3月實施Commission Delegated Regulation 2020/1182時,吡硫翁鋅被“出乎意料”地增加到違禁物質(zhì)清單里,幾十年來ZnPT通常用作抗真菌活性成分。“ZnPT現(xiàn)在被正式歸類為1B,”該公司說。

圖:Biocote在歐盟將吡啶硫酮鋅的毒性類別定義為1B之后,在全球范圍內(nèi)永久終止了吡啶硫酮鋅抗菌母粒的供應(yīng)。
圖片來源:BIOCOTE
委員會的裁決僅適用于歐盟市場。Biocote表示,ZnPT仍在全球其他地區(qū)使用,并表示在美國的幾家公司將ZnPT作為廣泛產(chǎn)品(包括洗發(fā)水和木質(zhì)防腐劑)的主要活性成分。盡管如此,該公司表示,它已決定永久停止向它的全球客戶供應(yīng)用于經(jīng)過處理的物品的含ZnPT添加劑。
Arxada公司,此前名為Lonza Specialty Ingredients,是吡啶硫酮鋅的重要供應(yīng)商,并且仍然致力于該產(chǎn)品。“ ZnPT是聚烯烴加工商使用最有效、最通用的抗菌添加劑之一。Arxada繼續(xù)支持ZnPT用于聚合物和紡織品應(yīng)用,并繼續(xù)大量投資于該化工。”該公司說。
該公司補(bǔ)充道:“隨著歐洲分類的更新,Arxada的監(jiān)管事務(wù)團(tuán)隊啟動了一個為了確保持續(xù)遵守生物殺滅劑法規(guī)(BPR,產(chǎn)品類型9)的重大項目。目的是要顯示法規(guī)第5.2條的批準(zhǔn)條件(減損)已經(jīng)得到滿足。該批準(zhǔn)將確保我們最貴的客戶可以在現(xiàn)在和將來繼續(xù)在防腐應(yīng)用中使用ZnPT。”
為PVC應(yīng)用提供保護(hù)
在軟質(zhì)PVC中,殺菌劑尤其重要,因為增塑劑成分可能特別容易受到微生物攻擊。Valtris Specialty Chemicals公司的Intercide和MicroChek Tradenames產(chǎn)品系列為PVC應(yīng)用提供了的一整套的殺菌劑產(chǎn)品。歐洲和亞太地區(qū)殺菌劑業(yè)務(wù)經(jīng)理Phil Clegg表示,該公司過去幾年在幾個地區(qū)的塑料市場上觀察到的一種關(guān)鍵趨勢是脫離砷生物殺滅劑,例如氧代雙吩惡砒(OBPA)。由于尚未注冊,無論是OBPA還是含OBPA的PVC物品均無法在歐盟獲得認(rèn)可。Clegg說,結(jié)果這造就了異噻唑啉酮替代方案的主導(dǎo)地位(Valtris是二氯正辛基異噻唑啉酮DCOIT和正辛基異噻唑啉酮OIT的主要廠商)。
Clegg稱,向歐洲化學(xué)局(ECHA)申請活性物質(zhì)和生物殺滅產(chǎn)品的批準(zhǔn)是一個漫長的過程,近年來,注冊有些延遲。“對于Valtris銷售的用于塑料的產(chǎn)品,本來預(yù)計現(xiàn)在能完成活性物質(zhì)的注冊,并且殺菌產(chǎn)品注冊的申請正在進(jìn)行中。實際上,由于巨大的工作量以及疫情導(dǎo)致的延遲,ECHA的工作普遍存在延誤。”
英國的脫歐也產(chǎn)生了影響。“此外,在有英國作為評估成員國的申請中,活性物質(zhì)的批準(zhǔn)已經(jīng)被延遲。這些申請已被重新分配給其他成員國,但這個過渡減緩了審批的速度。”他說。
在英國工作的Clegg表示,英國脫歐也意味著英國法規(guī)方面的一些不確定性。他說:“由于英國脫歐,我們現(xiàn)在在英國有重復(fù)的法規(guī)。” “最近在英國的活動集中在已經(jīng)批準(zhǔn)的活性物質(zhì)的重新批準(zhǔn)上;有關(guān)PT9(塑料)的剩余申請的時間表尚未發(fā)布。”
在美國,OBPA的使用已經(jīng)被批準(zhǔn)了。2021年6月,EPA在注冊審查的公共部分完成后發(fā)布了一項臨時決定。根據(jù)特洛伊公司(Troy Corporation,Arxada的一部分和OBPA制造商)的產(chǎn)品注冊主任Adrian Krygsman的說法,EPA的風(fēng)險評估草案和臨時決定草案結(jié)束了,并沒有關(guān)于OBPA的毒理學(xué)的危險信號,也沒有用作塑料工業(yè)防霉劑的擔(dān)憂 。
抗菌技術(shù)在改性行業(yè)的發(fā)展
去年,領(lǐng)先的材料設(shè)計公司Techmer PM達(dá)成了一項協(xié)議,旨在加強(qiáng)和擴(kuò)大與卡普諾(Cupron)的銅基抗菌專利技術(shù)的長期合作伙伴關(guān)系。Techmer現(xiàn)在是卡普諾的主要技術(shù)合作伙伴、制造商以及廣泛市場應(yīng)用的銷售和營銷代表。
卡普諾是一家位于弗吉尼亞州里士滿市的銅抗菌技術(shù)公司,生產(chǎn)一種粉末形式的活性氧化銅成分,Techmer在其聚合物配混過程中將其封裝。據(jù)說該添加劑有助于消滅細(xì)菌,并賦予各種成品持久的抗菌、抗異味和表面增強(qiáng)的特性。據(jù)說它適合在運輸、醫(yī)療保健、娛樂和消費產(chǎn)品以及零售和工作場所環(huán)境等領(lǐng)域使用。
Techmer PM產(chǎn)品開發(fā)經(jīng)理Kaan Serpersu說:“ 為了在由各種聚合物制成的模制品、纖維或薄膜中實現(xiàn)最佳的分散、顏色控制和加工穩(wěn)定性,Techmer在配方中使用了卡普諾添加劑。”
Techmer PM市場開發(fā)總監(jiān)Steve Loney說:“盡管我們的銅材料的本色為銹紅色,但我們的顏色專家可以根據(jù)客戶的特定顏色需求來定制配方。” “在表演服裝以及在Techmer內(nèi)部纖維生產(chǎn)線上的其他面料中可以看到定制的銅色。”

圖:卡普諾與美國改性廠商Techmer PM合作提供一種粉末形式的氧化銅,該氧化銅據(jù)稱可以賦予持久的抗菌和抗異味性能。
圖片來源:BUSINESS WIRE
卡普諾添加劑已用于無紡布的擠出涂層,用來制造醫(yī)院里的手術(shù)衣。Loney說,人們對塑料膜中抗菌劑的興趣增加了。“在塑料膜中摻入抗菌劑已擴(kuò)展到醫(yī)療保健區(qū)域之外,并在建筑材料中用來對付霉菌和其他真菌。具體的應(yīng)用包括用來保護(hù)房屋爬行空間的墻壁和薄膜中的蒸汽阻隔層。”他說。
“事實證明,卡普諾添加劑是這些應(yīng)用的絕佳功能選擇。銅色可幫助建筑工人正確地布置薄膜,將銅側(cè)朝著最容易污染的一面。” Loney補(bǔ)充說。
2021年5月,埃萬特(Avient)引入了三種含有抗菌添加劑的GLS熱塑性彈性體(TPE)配方。根據(jù)JIS Z2801和ASTM G21-15標(biāo)準(zhǔn)測試,這些添加劑通過抑制細(xì)菌生長(99.9%或更高)并抵抗真菌和霉菌生長來保護(hù)成型塑料零件。這些牌號在Versaflex和OnFlex產(chǎn)品家族下找到。潛在的應(yīng)用包括消費電子產(chǎn)品、個人護(hù)理產(chǎn)品的握把以及汽車應(yīng)用,例如杯架墊和HVAC密封件。

圖:埃萬特的抗菌GLS TPE抑制99.9%或更多的細(xì)菌生長,并抵抗真菌生長。
圖片來源:埃萬特/GETTY IMAGES
新的TPE改性材料可保護(hù)成品零件的紋理和光滑表面,讓微生物無法在上面生長。埃萬特宣稱它們的配方使用了的Arxada的EPA注冊抗菌劑,據(jù)了解是吡硫翁鋅。它們在美國和亞洲都能買到。其他抗菌的配方正在開發(fā)中。
病毒和細(xì)菌可以在塑料表面存活幾天,這意味著物品表面可能是引起交叉感染的持續(xù)風(fēng)險??偛课挥谟腟ymphony說,其D2P抗菌母粒旨在解決這個問題。它沒有指出具體活性成分是什么,但說D2P對革蘭氏陽性和陰性細(xì)菌、霉菌、藻類,真菌和病毒有效。D2P抗菌母粒已經(jīng)獲得FDA批準(zhǔn)用于食品包裝,適用于所有類型的聚烯烴塑料以及用于包裹面包的聚酯薄膜。加拿大衛(wèi)生部還批準(zhǔn)了D2P用于面包包裝。該公司說,商業(yè)使用已經(jīng)開始,最近客戶主導(dǎo)的在塑料水管和水箱上的實驗也成功完成了。
瑞士公司Sukano表示,它已經(jīng)開發(fā)了一系列抗病毒母粒,以防止塑料零件成為病毒的可能傳播體。最初它們是針對新冠病毒的個人防護(hù)設(shè)備(PPE)開發(fā)的,現(xiàn)在可以用于更多的應(yīng)用和聚合物。
該公司表示,客戶要求在PPE以外的應(yīng)用提供病毒傳播保護(hù)的需求越來越多,例如一些工業(yè)應(yīng)用或一些經(jīng)常被觸摸但不一定經(jīng)常清潔的耐用品。例如升降機(jī)中的面板和按鍵,這些物體表面一天中會多次與不同的人產(chǎn)生接觸。
Sukano已在經(jīng)過認(rèn)證的專業(yè)從事微生物學(xué)測試的外部實驗室中進(jìn)行了測試。結(jié)果證實了母粒對各種病毒的有效性,在最初的30分鐘內(nèi),物品表面上的病毒減少多達(dá)99.9%。該公司業(yè)務(wù)開發(fā)經(jīng)理Onno Treur說:“我們將母粒進(jìn)一步開發(fā)到其它載體材料上,例如ABS、PC、PA、PET和PLA。” “這使得抗病毒表面保護(hù)得到的更廣泛的應(yīng)用,例如在電子電器市場。”
Polygiene收購的公司Addmaster(一家因抗菌產(chǎn)品而聞名的添加劑和母粒公司)表示,廣泛的測試表明,其Biomaster抗菌劑對新冠病毒具有活性。根據(jù)ISO 21702對非多孔表面(包括塑料)進(jìn)行的測試顯示,新冠病毒在15分鐘內(nèi)減少了68%,在四個小時內(nèi)減少了99%以上(圖2)。

許多(但不是全部)Biomaster基于銀離子技術(shù)。Addmaster以粉末、液體和母粒的形式銷售它們。Mocom是一家總部位于德國的改性材料公司,它把Biomaster用在它的Alcom HM改性材料中??咕噶5幕A(chǔ)樹脂有多種選擇,目的是抑制衛(wèi)生應(yīng)用中的微生物生長。該改性材料廠商說,HM產(chǎn)品“將保護(hù)塑料免受微生物侵害與客戶有關(guān)特定顏色和材料特性(例如穩(wěn)定,沖擊強(qiáng)度或增強(qiáng))的個性化要求結(jié)合在一起。”
Mocom說,它使用的Biomaster技術(shù)基于銀離子技術(shù),并且符合《歐盟殺菌劑法規(guī)》歐盟528/2012以及它的第95條。該公司表示:“ Alcom HM改性材料被歸類為經(jīng)過處理過的物品,并符合第58條的要求。”
根據(jù)Mocom的說法,塑料表面上的銀離子已經(jīng)針對50多種不同類型的細(xì)菌進(jìn)行了測試,例如大腸桿菌、彎曲桿菌、軍團(tuán)菌、MRSA和沙門氏菌。它說,銀離子的抗菌作用在15分鐘后就會很明顯,通常24小時后細(xì)菌減少量高達(dá)99.9%。

來源:榮格塑料工業(yè)